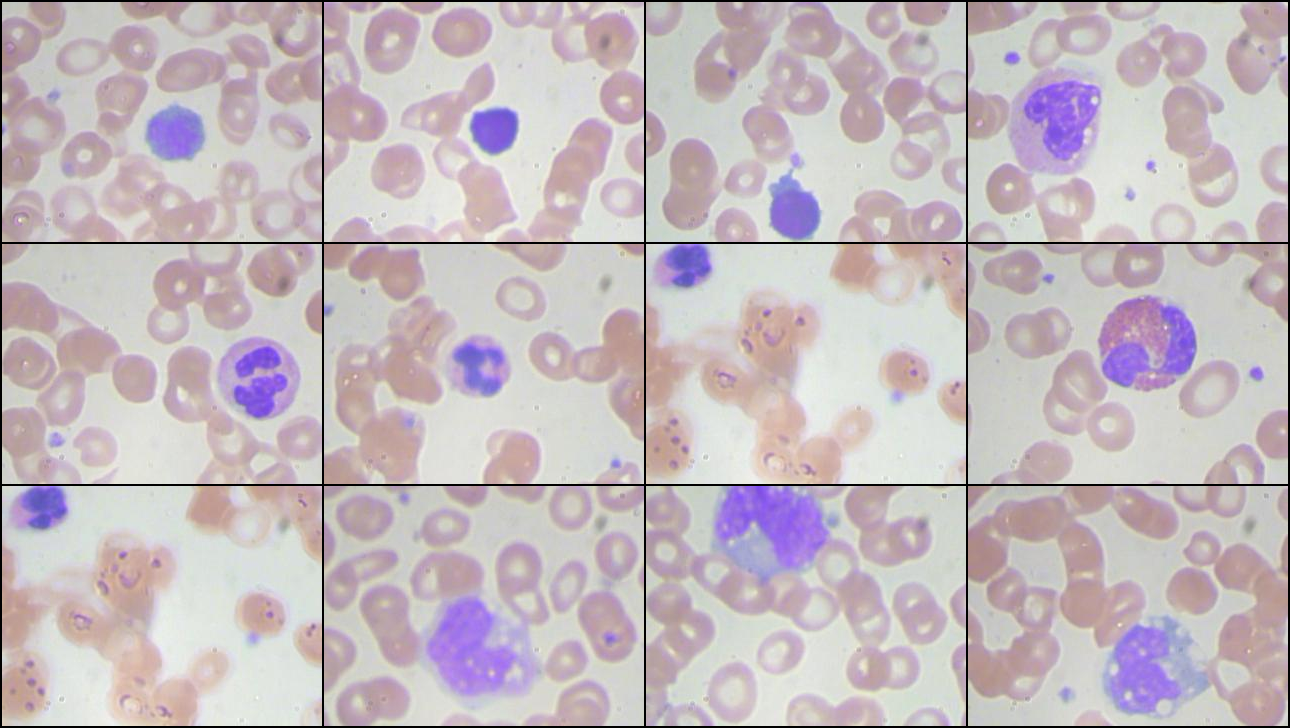

주로 다음의 3가지를 개인적으로 사용함.
save_image: 파일 직접 저장, 배치 그리드 배열, 정규화/시각화 기능 내장encode_jpeg: 손실 압축, 더 작은 파일 크기, RGB/Grayscale만 지원encode_png: 무손실 압축, 더 큰 파일 크기, RGBA 지원 가능
관련 gist
https://gist.github.com/dsaint31x/c85521ce40c10787f04a7e5909373d22
dl_torchvision_save_images.ipynb
dl_torchvision_save_images.ipynb. GitHub Gist: instantly share code, notes, and snippets.
gist.github.com
https://dsaint31.tistory.com/402
[DIP] Image Format (summary)
Digital Image 들의 대표적인 encoding 방식들은 다음과 같음:BMP (Bitmap):비트맵(bitmap) 방식. extension(확장자)가 bmp임.압축도 가능하나 주로 압축되지 않는 방식으로 많이 사용됨 (1998년 Windows2.0과 함께 MS
dsaint31.tistory.com
1. torchvision.utils.save_image
torchvision.utils 모듈의 save_image 를 통해 tensor 객체를 image 로 저장할 수 있음.
- 실은, 여러 이미지의 배치(batch)를 하나의 그리드(grid) 형태로 저장하는 데 주로 사용되는 함수임.
- 때문에 단일 이미지인 경우,
nrow는 무시되나padding은 여전히 영향을 줌.
torchvision.utils.save_image(
tensor: torch.Tensor,
fp: str | Path | BinaryIO,
format: Optional[str] = None,
*,
nrow: int = 8,
padding: int = 2,
pad_value: float = 0.0,
normalize: bool = False,
value_range: Optional[Tuple[float, float]] = None,
scale_each: bool = False,
)
tensor:- 저장할 이미지 텐서 (dtype인 float32여야 함).
- [C, H, W] or [N, C, H, W]
- [0.0, 1.0] 이어야 함. (아니면 clamp 발생.)
fp: 저장할 파일 경로 또는 파일 객체format:fp의 extension으로 자동으로 설정되나 지정도 가능. "png", "jpeg"nrow: batch 형태일 경우, 한 줄에 표시될 이미지 수.padding: 이미지 사이의 패딩 pixel 수.pad_value: padding으로 채울 값.normalize:value_rage와 같이 정규화할 범위지정을 통한 정규화 수행여부.scale_each: batch의 각 이미지별로 개별 정규화.
[0.0,1.0] 사이의 float값으로 구성된 input을 가정하며, 해당 범위로 clamp 처리됨.
그리고 0.0과 1.0을 0과 255로 매핑하여 scaling함.
예제 코드
import torch
import torchvision.utils as utils
import torchvision.transforms as transforms
# 주석 처리를 해보고 돌려볼 것.
original_img = original_img.to(dtype=torch.float32)
original_img /= 255.
# 1. 단일 이미지 저장
utils.save_image(original_img.to(dtype=torch.float32), 'single.png')
# 2. 배치 이미지를 그리드로 저장
batch_images = torch.stack([original_img] * 16, dim=0)
print(f"{batch_images.shape = }")
# batch_images = torch.rand(16, 3, 64, 64) # [N, C, H, W]
utils.save_image(
batch_images.to(dtype=torch.float32),
'grid.png',
nrow=4, # 4x4 그리드
padding=2, # 이미지간 2픽셀 간격
pad_value=1.0 # 흰색 패딩
)
# 3. 정규화가 필요한 경우 (-1~1 범위를 0~1로 처리하고 이를 다시 0-255로 저장)
normalized_images = torch.rand(8, 3, 32, 32) * 2 - 1 # [-1, 1] 범위
utils.save_image(
normalized_images.to(dtype=torch.float32),
'w_normalized.png',
nrow=4,
normalize=True,
value_range=(-1, 1) # 입력 범위 지정
)
utils.save_image(
normalized_images.to(dtype=torch.float32),
'wo_normalized.png',
nrow=4,
normalize=False,
# range=(-1, 1) # 입력 범위 지정
)
# 4. 각 이미지별 개별 정규화
varied_range_images = torch.stack([
torch.rand(3, 32, 32) * 0.5, # [0, 0.5] 범위
torch.rand(3, 32, 32) * 2, # [0, 2.0] 범위
torch.rand(3, 32, 32) * 0.1 + 0.9 # [0.9, 1.0] 범위
])
print(f"{varied_range_images.shape = }")
utils.save_image(
varied_range_images.to(dtype=torch.float32),
'scale_each.png',
nrow=3,
scale_each=True # 각각 개별 정규화
)
2. torchvision.io.encode_jpeg
torchvision.io 모듈의 함수로, tensor 객체를 jpeg으로 인코딩한 bytes객체를 반환함.
- 메모리에서 이미지 텐서를 JPEG 형식의 바이트 데이터로 변환하는 함수임.
- 파일로 저장하거나 네트워크 전송 등에 활용 가능함.
torchvision.io.encode_jpeg(
input: torch.Tensor,
quality: int = 75
) -> torch.Tensor
input: 인코딩할 이미지 텐서.[3, H, W]또는[1, H, W]형태의 uint8 타입- 반드시 [0,255] 범위의 값이어야 함
quality: JPEG 압축 품질. 1(최저품질)~100(최고품질) 범위
반환값: JPEG 바이트 데이터가 담긴 1차원 uint8 텐서
import torch
import torchvision.io as io
# uint8 텐서 준비 (0-255 범위)
tensor = torch.randint(0, 256, (3, 224, 224), dtype=torch.uint8)
# JPEG 바이트로 인코딩
jpeg_bytes = io.encode_jpeg(tensor, quality=90)
# 파일로 저장
with open('output.jpg', 'wb') as f:
f.write(jpeg_bytes.numpy().tobytes())
torchvision.io.encode_png
torchvision.io 모듈의 encode_png를 통해 tensor 객체를 PNG 바이트(bytes객체)로 인코딩.
- 메모리에서 이미지 텐서를 PNG 형식의 바이트 데이터로 변환하는 함수임.
- 무손실 압축으로 정확한 픽셀 값 보존이 필요한 경우에 사용함.
torchvision.io.encode_png(
input: torch.Tensor,
compression_level: int = 6
) -> torch.Tensor
- input : 인코딩할 이미지 텐서.
[3, H, W],[1, H, W], 또는[4, H, W]형태의 uint8 타입 compression_level: PNG 압축 레벨. 0(압축없음)~9(최대압축) 범위
반환값: PNG 바이트 데이터가 담긴 1차원 uint8 텐서
import torch
import torchvision.io as io
# uint8 텐서 준비 (0-255 범위)
tensor = torch.randint(0, 256, (3, 224, 224), dtype=torch.uint8)
# PNG 바이트로 인코딩
png_bytes = io.encode_png(tensor, compression_level=6)
# 파일로 저장
with open('output.png', 'wb') as f:
f.write(png_bytes.numpy().tobytes())
같이보면 좋은 자료
2025.06.17 - [Python] - [torchvision] image로부터 torch.tensor 객체 얻기
[torchvision] image로부터 torch.tensor 객체 얻기
1. torchvision.io.decode_imagetorchvision.io.decode_image 함수는 이미지 파일(경로 또는 raw 바이트 데이터)을 PyTorch 텐서로 디코딩하는 함수.torchvision에서 실제 이미지를 로딩하여 PyTorch Tensor 객체를 얻는 데
ds31x.tistory.com
2024.12.03 - [Python] - [Py] io.StringIO 와 io.BytesIO
[Py] io.StringIO 와 io.BytesIO
io.StringIO와 io.BytesIO는Python의 io 모듈에서 제공하는 메모리 기반 파일 객체(memory-based file object)임.이들은 데이터를 메모리에 저장하면서 파일처럼 다룰 수 있는 기능을 제공함: Stream Object두 클래
ds31x.tistory.com
'Python' 카테고리의 다른 글
| Pillow 사용법 - Basic 03 - Image Enhance (0) | 2025.07.01 |
|---|---|
| Pillow 사용법 - Basic 01 (2) | 2025.06.30 |
| torchvision.datasets.ImageFolder 사용하기. (0) | 2025.06.17 |
| [torchvision] image로부터 torch.tensor 객체 얻기 (0) | 2025.06.17 |
| [torchvision] transforms.v2, transforms.v2.functional, 그리고 kernel (0) | 2025.06.17 |